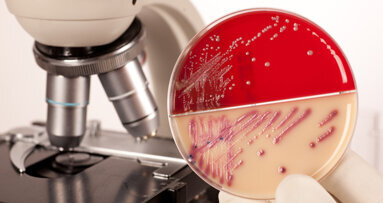
Antibakterielle ­Beschichtungen untersucht

Wie belastend ist ein chirurgischer Eingriff für Studierende in der Zahnmedizin, wenn sie ihn selbst durchführen? Eine spanische Forschungsgruppe hat genau das untersucht. Nicht über Befragungen, sondern über eine Analyse biologischer Marker im Speichel. Die Studie stammt von einem Team der Universität Alcalá und der Universidad Alfonso X El Sabio in Madrid. Sie wurde im Mai 2025 vorläufig in der Fachzeitschrift Frontiers in Medicine angenommen. Ziel war es, herauszufinden, ob ein chirurgischer Arbeitstag in der zahnärztlichen Ausbildung messbare Auswirkungen auf den Körper hat. Genauer: auf Stress- und Entzündungsprozesse, wie sie im Speichel abgebildet werden.
Dazu wurden Speichelproben von 21 postgradualen Studierenden der Oralchirurgie untersucht. Die Teilnehmenden führten einen implantologischen Eingriff durch und die Proben wurden direkt vor und nach dem Eingriff genommen. Zusätzlich beantworteten die Studierenden einen Fragebogen zum eigenen Stressempfinden. Gemessen wurden vier Parameter. Cortisol steht für die akute Stressreaktion des Körpers. IL-6 und IL-1β sind Entzündungsmarker. CRP, das C-reaktive Protein, ist ein Hinweis auf systemische Entzündungen. Die Ergebnisse fielen differenziert aus. Der Cortisolwert sank nach dem Eingriff. Gleichzeitig stieg der IL-6-Wert deutlich an. IL-1β zeigte keine auffällige Veränderung. Bei Studierenden mit erhöhtem IL-6 ließ sich auch ein Anstieg des CRP beobachten.
Auffällig war außerdem die Beziehung zwischen subjektivem Stress und gemessenem Cortisol. Wer sich gestresst fühlte, wies im Speichel eher niedrigere Cortisolwerte auf. Die Autoren beschreiben diesen Zusammenhang zwar, deuteten diesen aber nicht abschließend. Einflussfaktoren wie Geschlecht, akademisches Jahr oder Raucherstatus hatten keinen messbaren Effekt. Die Teilnehmenden waren im Schnitt 25,5 Jahre alt.
Studierende stehen unter Stress, der nicht nur psychisch spürbar ist, sondern sich auch biochemisch ausdrückt. Für viele ist das keine Überraschung. Neu ist, dass man diesen Effekt mit einfachen Mitteln sichtbar machen kann. Daraus ergibt sich kein unmittelbarer Handlungszwang, aber eine Gelegenheit. Wenn sich Belastung nachweisen lässt, können Bildungseinrichtungen und Kliniken anders damit umgehen. Nicht jede Form von Stress ist vermeidbar, schon gar nicht im OP. Aber wie Studierende begleitet, vorbereitet und entlastet werden, liegt durchaus im Gestaltungsspielraum.



 Österreich / Österreich
Österreich / Österreich
 Bosnien und Herzegowina / Босна и Херцеговина
Bosnien und Herzegowina / Босна и Херцеговина
 Bulgarien / България
Bulgarien / България
 Kroatien / Hrvatska
Kroatien / Hrvatska
 Tschechien & Slowakei / Česká republika & Slovensko
Tschechien & Slowakei / Česká republika & Slovensko
 Frankreich / France
Frankreich / France
 Deutschland / Deutschland
Deutschland / Deutschland
 Griechenland / ΕΛΛΑΔΑ
Griechenland / ΕΛΛΑΔΑ
 Ungarn / Hungary
Ungarn / Hungary
 Italien / Italia
Italien / Italia
 Niederlande / Nederland
Niederlande / Nederland
 Nordic / Nordic
Nordic / Nordic
 Polen / Polska
Polen / Polska
 Portugal / Portugal
Portugal / Portugal
 Rumänien & Moldawien / România & Moldova
Rumänien & Moldawien / România & Moldova
 Slowenien / Slovenija
Slowenien / Slovenija
 Serbien & Montenegro / Србија и Црна Гора
Serbien & Montenegro / Србија и Црна Гора
 Spanien / España
Spanien / España
 Schweiz / Schweiz
Schweiz / Schweiz
 Türkei / Türkiye
Türkei / Türkiye
 Großbritannien und Irland / UK & Ireland
Großbritannien und Irland / UK & Ireland
 International / International
International / International
 Brasilien / Brasil
Brasilien / Brasil
 Kanada / Canada
Kanada / Canada
 Lateinamerika / Latinoamérica
Lateinamerika / Latinoamérica
 USA / USA
USA / USA
 China / 中国
China / 中国
 Indien / भारत गणराज्य
Indien / भारत गणराज्य
 Pakistan / Pākistān
Pakistan / Pākistān
 Vietnam / Việt Nam
Vietnam / Việt Nam
 ASEAN / ASEAN
ASEAN / ASEAN
 Israel / מְדִינַת יִשְׂרָאֵל
Israel / מְדִינַת יִשְׂרָאֵל
 Algerien, Marokko und Tunesien / الجزائر والمغرب وتونس
Algerien, Marokko und Tunesien / الجزائر والمغرب وتونس
 Naher Osten / Middle East
Naher Osten / Middle East

To post a reply please login or register